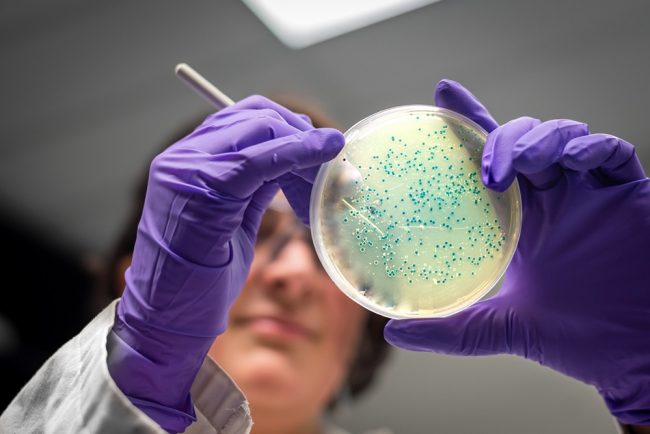

В России стали меньше умирать от болезней системы кровообращения
В России стали меньше умирать от болезней системы кровообращения В России впервые за 30 лет удалось на треть снизить показатель смертности от болезней системы кровообращения. А в 2023 году он бы самым низким за последние десятилетия. Об успехах реализации Федерального проекта по борьбе с сердечно-сосудистыми заболеваниями рассказала заместитель генерального директора ФГБУ «НМИЦК им. ак. Е.И.…

Согласно


